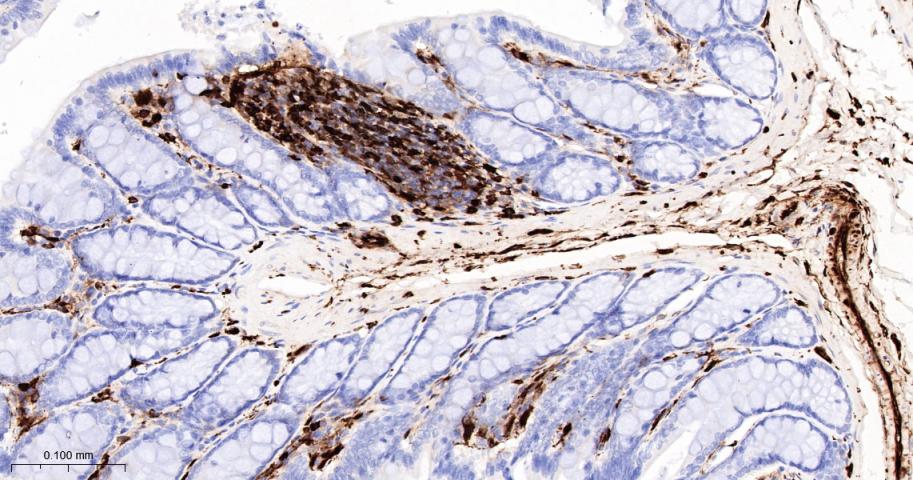
S100钙结合蛋白A4重组兔单抗

S100钙结合蛋白A4重组兔单抗
Rrmab?兔单抗

货号:bsm-55522R
产品详情
相关标记
相关产品
相关文献
常见问题
概述
产品编号
bsm-55522R
产品类型
重组兔单抗、mIHC精品抗体
英文名称
S100A4 Recombinant Rabbit mAb
中文名称
S100钙结合蛋白A4重组兔单抗
英文别名
MTS1; 18A2; 42A; CAPL; FSP1; P9KA; PEL98; metastasin; pk9a; RNP9KA; S10A4_BOVIN; S100A4; Placental calcium-binding protein homolog; S100 calcium-binding protein A4; S10A4_CANLF; S10A4_HUMAN; Calvasculin; Placental calcium-binding protein; Protein Mts1; S10A4_MOUSE; Metastatic cell protein; Protein 18A2; S10A4_RAT; Nerve growth factor-induced protein 42A; P9K;
抗体来源
Rabbit
免疫原
Recombinant Mouse S100A4 protein
亚型
IgG
性状
Liquid
纯化方法
Affinity Purification
克隆类型
Recombinant
克隆号
SB100
理论分子量
12 kDa
检测分子量
12 kDa
储存液
PBS with 100 μg/ml BSA,0.15% ProClin300 and 50% glycerol.
研究领域
SWISS
Gene ID
保存条件
Store at -20 ℃ for one year. Avoid repeated freeze/thaw cycles.
注意事项
This product as supplied is intended for research use only, not for use in human, therapeutic or diagnostic applications.
数据库链接
产品介绍
S100A4属于钙离子结合蛋白S100蛋白家族,参与细胞骨架及细胞膜的相互作用、钙离子信号传递和细胞生长及分化等,在细胞内、外均可发挥作用,增加肿瘤细胞的运动、侵袭能力,降低细胞间黏附力,重塑细胞外基质,促进细胞异常增生及血管生成,被称为转移促进基因。
背景资料
The protein encoded by this gene is a member of the S100 family of proteins containing 2 EF-hand calcium-binding motifs. S100 proteins are localized in the cytoplasm and/or nucleus of a wide range of cells, and involved in the regulation of a number of cellular processes such as cell cycle progression and differentiation. S100 genes include at least 13 members which are located as a cluster on chromosome 1q21. This protein may function in motility, invasion, and tubulin polymerization. Chromosomal rearrangements and altered expression of this gene have been implicated in tumor metastasis.

产品应用
| 应用 | 已检合格种属 | 预测种属 | 推荐稀释比例 |
|---|---|---|---|
| WB | Human | Mouse, Rat | 1: 500-2000 |
| IHC-P | Human, Mouse, Rat | 1:100-500 | |
| IHC-F | Human, Mouse, Rat | 1:100-500 | |
| IF | Human, Mouse, Rat | 1:100-500 | |
| Flow-Cyt | Human | Mouse, Rat | 1:50-100 |
交叉反应
交叉反应: Human, Mouse, Rat
相关产品
暂无相关产品
靶标
基因名
S100A4
蛋白名
Protein S100-A4
亚基
Homodimer. Interacts with PPFIBP1 in a calcium-dependent mode.
组织特异性
Ubiquitously expressed.
相似性
Belongs to the S-100 family.
Contains 2 EF-hand domains.
Contains 2 EF-hand domains.
标记抗体
暂无标记数据
同靶标产品
暂无同靶标产品
相关文献
提示: 发表研究结果有使用 bsm-55522R 时请让我们知道,以便我们可以引用参考文章。作为回馈,资料提供者将获得我们送上的小礼品。
暂无相关文献
常见问题
暂无常见问题